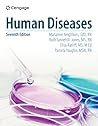
Human Diseases

32,410 books
—
123,427 voters
Katherine Whitehead
https://www.goodreads.com/kcw_325
Lover and friend hast thou put far from me, and mine acquaintance into darkness. Psalm 88
“I may have lost my heart, but not my self-control. ”
― Emma
― Emma
“It's not because I want to make out with her."
Hold on." He grabbed a pencil and scrawled excitedly at the paper as if he'd just made a mathematical breakthrough and then looked back up at me. "I just did some calculations, and I've been able to determine that you're full of shit”
― Looking for Alaska
Hold on." He grabbed a pencil and scrawled excitedly at the paper as if he'd just made a mathematical breakthrough and then looked back up at me. "I just did some calculations, and I've been able to determine that you're full of shit”
― Looking for Alaska
“The only way out of the labyrinth of suffering is to forgive.”
― Looking for Alaska
― Looking for Alaska
“Imagining the future is a kind of nostalgia. (...) You spend your whole life stuck in the labyrinth, thinking about how you'll escape it one day, and how awesome it will be, and imagining that future keeps you going, but you never do it. You just use the future to escape the present.”
― Looking for Alaska
― Looking for Alaska
“When adults say, "Teenagers think they are invincible" with that sly, stupid smile on their faces, they don't know how right they are. We need never be hopeless, because we can never be irreparably broken. We think that we are invincible because we are. We cannot be born, and we cannot die. Like all energy, we can only change shapes and sizes and manifestations. They forget that when they get old. They get scared of losing and failing. But that part of us greater than the sum of our parts cannot begin and cannot end, and so it cannot fail.”
― Looking for Alaska
― Looking for Alaska
What's the Name of That Book???
— 120816 members
— last activity 39 minutes ago
Can't remember the title of a book you read? Come search our bookshelves and discussion posts. If you don’t find it there, post a description on our U ...more
Katherine’s 2025 Year in Books
Take a look at Katherine’s Year in Books, including some fun facts about their reading.
Katherine hasn't connected with her friends on Goodreads, yet.
Favorite Genres
Polls voted on by Katherine
Lists liked by Katherine